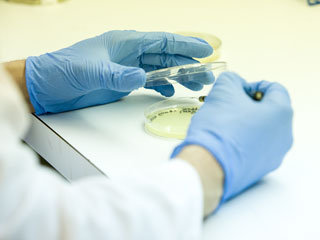
Student tests cutures in petri dish

Microbiology and Molecular Genetics
What does microbiology/cell and molecular genetics include?
Microbiology/cell and molecular genetics are founded on experimentation conducted
in research laboratories, hospitals and field studies. Microbiologists study how microorganisms
interact with their environment, to harness their power for biotechnology. Cell and
molecular biologists investigate cellular processes using genetic and biochemical
analyses.
Why microbiology/cell and molecular genetics at OSU?
Microbiology/cell and molecular biology majors at OSU study how microorganisms and
other cells interact with their environment and what processes happen within cells.
Understanding microorganisms and other cells can lead to the advances in biotechnology
and new strategies to treat diseases. Here, you will work with living organisms that
span the spectrum of microbial life and animal cells that contribute to immunological
responses. The Department of Microbiology and Molecular Genetics partners with various
scholar programs on campus, which provides support for college preparation, connects
you to various resources and nurtures your individual academic development.